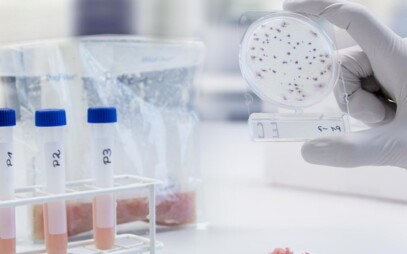
Fakulta potravinářské a biochemické technologie

Zemědělství a veterina
18 škol a fakult
💡Propojujeme teorii s praxí, abyste uspěli v reálném světě businessu. ➡️ NEWTON University
Fakulta veterinární hygieny a ekologie
- Bezpečnost a kvalita potravin
- Hygiena a technologie potravin
- Chov zvířat, výživa zvířat a biochemie
a dalších 8 programů
Lesnická a dřevařská fakulta
- Arboristika
- Biomateriály
- Design nábytku
a dalších 28 programů
Fakulta tropického zemědělství
- Agri-food Systems and Rural Development (EN)
- Agricultural Development - International Development and Agricultural Economics - double degree (EN)
- Agriculture in Tropics and Subtropics (EN)
a dalších 10 programů
Fakulta agrobiologie, potravinových a přírodních zdrojů
- Agriculture and Food (EN)
- Akvakultura a péče o vodní ekosystémy
- Aplikovaná zoologie
a dalších 39 programů
Fakulta chemická
- Food Chemistry (EN)
- Chemie a technologie potravin - Chemie a technologie potravin
- Potravinářská chemie
- Potravinářská chemie a biotechnologie
Kam na vysokou školu?
Vyplňte test a během 5 minut to zjistíte.
Fakulta lesnická a dřevařská
- Aplikovaná geoinformatika a DPZ v lesnictví
- Biologie lesa
- Dřevařské inženýrství
a dalších 17 programů
Fakulta rybářství a ochrany vod
- Fishery (EN)
- Fishery and protection of waters (EN)
- Ochrana vod
a další 4 programy
Kam na vysokou školu?
Vyplňte test a během 5 minut to zjistíte.
Fakulta zemědělská a technologická
- Agroekologie a aplikovaná ekologie
- Agropodnikání
- Biologie a ochrana zájmových organismů
a dalších 13 programů
Agronomická fakulta
- Agrobyznys
- Agroekologie
- Animal Production (EN)
a dalších 41 programů
Fakulta potravinářské a biochemické technologie
- Chemie a analýza potravin a přírodních produktů
- Chemie a technologie potravin
- Potraviny a přírodní produkty
- Technologie potravin
Technická fakulta
- Agricultural Engineering (EN)
- Engineering of Agricultural Technological Systems (EN)
- Informační a řídicí technika v agropotravinářském komplexu
a další 4 programy
Zahradnická fakulta
- Cirkulární horti-produkce
- European Horticulture (EN)
- Floristická tvorba
a dalších 11 programů
Obstáli byste u přijímaček na VŠ?
Zkuste si SCIO testy zdarma.
Fakulta technologická ve Zlíně
- Biomateriály a kosmetika
- Biomateriály a kosmetika (EN)
- Gastronomické technologie
a dalších 11 programů
Fakulta životního prostředí
- Environmental Data Science (EN)
- Environmental Engineering (EN)
- Geografické informační systémy a dálkový průzkum Země v životním prostředí
a dalších 12 programů
Fakulta veterinárního lékařství
- Dogs, Cats and Pets Diseases (EN)
- Genetics, breeding and animal reproduction (EN)
- Genetika, plemenitba a reprodukce zvířat
a dalších 14 programů